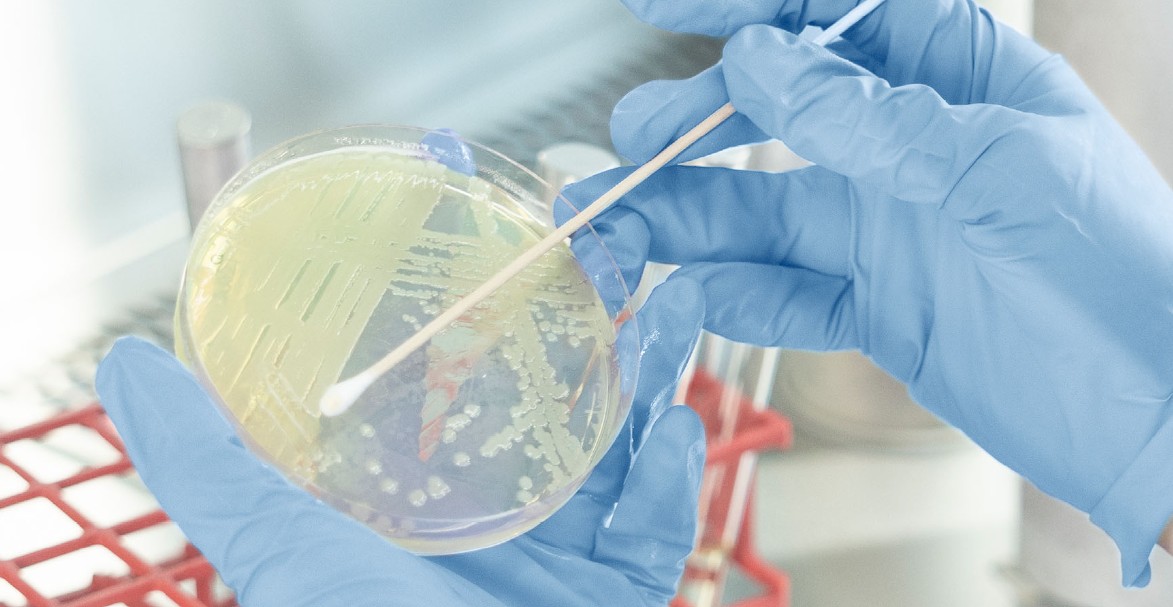
Basilea Pharmaceutica: Innovative Therapien gegen tödliche Bakterien und Pilze

Die Beteiligungsgesellschaft BB Biotech erhöht nach einem erfolgreichen Geschäftsjahr 2017 die Dividende auf 3.30 CHF je Aktie. Im Vorjahr hatte das Unternehmen trotz eines Gesamtjahresverlustes 2.75 CHF pro Aktie ausgeschüttet. Das Portfolio der Gesellschaft habe sich 2017 gut entwickelt, heisst es in der Medienmitteilung des Unternehmens am Freitag.
Für das vierte Quartal 2017 weist BB Biotech auf Basis noch ungeprüfter Zahlen einen Verlust von 156 Mio CHF aus. Im Vorjahr hatte das Unternehmen einen Nettoverlust von 24 Mio CHF verbucht. Für das Gesamtjahr liegt der Gewinn laut ersten Berechnungen bei 688 Mio CHF. Zum Vergleich: Der Jahresverlust nach Steuern hatte 2016 bei 802 Mio CHF gelegen.
Starke Gesamtperformance in 2017
Dank einer starken Performance liegt die Gesamtrendite von BB Biotech laut Meldung für 2017 bei 23.1% in CHF (+13.1% in EUR). Das Portfolio habe sich gut entwickelt, wobei vor allem das vierte Quartal sehr volatil war. Der Innere Wert stieg um 23.4% in CHF, 12.5% in EUR und 29.2% in USD. Er übertraf damit den Nasdaq Biotech Index um 7.5%.
Im vierten Quartal sorgten die schwankungsstärkeren Märkte dafür, dass das Portfolio im Einklang mit dem Sektor um 4% an Wert verlor. Gleichzeitig büsste der Aktienkurs von BB Biotech aber lediglich um 1% in CHF ein.
Vor allem die erhöhte Schwankungsbreite bei den grösseren Biotechnologie-Unternehmen habe im vierten Quartal eine beachtliche kurzfristige Abwertung nach sich gezogen, heisst es in der Mitteilung weiter. Im Gegensatz dazu setzten kleinere und mittlere Biotech-Firmen ihre Kursgewinne dank positiver klinischer Versuchsergebnisse und zahlreicher Produktlancierungen fort.
Swedish Orphan Biovitrum-Beteiligung veräussert
Mit Blick auf das Portfolio wurde im vierten Quartal die restliche Beteiligung an Swedish Orphan Biovitrum (SOBI) veräussert. Im Large-Cap-Bereich nahm BB Biotech Gewinne bei Novo Nordisk nach deren starker Erholung mit und investierte die Mittel während eines heftigen Ausverkaufs Ende Oktober in Celgene.
Im Small- und Mid-Cap-Bereich stockte BB Biotech das Engagement in Radius Health, Macrogenics und Esperion auf und realisierte nach starken Kursavancen Gewinne bei Juno Therapeutics, Idorsia und Alnylam. BB Biotech partizipierte auch an der Privatplatzierung von Cidara Therapeutics.
Für das gerade angelaufene Geschäftsjahr 2018 geht BB Biotech davon aus, dass der Sektor und das eigene Portfolio von bedeutenden Produktzulassungen und Meilensteinen profitieren werden.
Die Aktien der BB Biotech sind an der SIX Swiss Exchange kotiert. Zuletzt wurden Kurse von um die 69.10 CHF gestellt. Bei einer Ausschüttung von 3.30 CHF liegt die Rendite bei 4.7%.
hr/cp